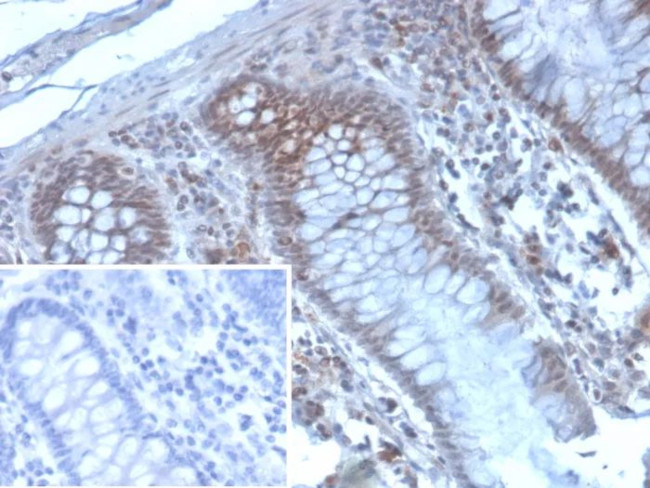
EZH2/KMT6 Antibody in Immunohistochemistry (Paraffin) (IHC (P))

Search
NeoBiotechnologies
EZH2/KMT6 Monoclonal Antibody (EZH2/4194)
{{$productOrderCtrl.translations['antibody.pdp.commerceCard.promotion.promotions']}}
{{$productOrderCtrl.translations['antibody.pdp.commerceCard.promotion.viewpromo']}}
{{$productOrderCtrl.translations['antibody.pdp.commerceCard.promotion.promocode']}}: {{promo.promoCode}} {{promo.promoTitle}} {{promo.promoDescription}}. {{$productOrderCtrl.translations['antibody.pdp.commerceCard.promotion.learnmore']}}
产品信息
2146-MSM4-P1
种属反应
宿主/亚型
分类
类型
克隆号
抗原
偶联物
形式
浓度
纯化类型
保存液
内含物
保存条件
运输条件
产品详细信息
Positive Control: HeLa MCF7 testis or prostate tissue. U-2 OS or HEK-293 whole cell lysates. Human tonsil
Cellular Location: Nucleus.
靶标信息
EZH2 (Histone-lysine N-methyltransferase) is a member of the Polycomb-group (PcG) family. PcG family members form multimeric protein complexes, which are involved in maintaining the transcriptional repressive state of genes over successive cell generations. This protein associates with the embryonic ectoderm development protein, the VAV1 oncoprotein, and the X-linked nuclear protein. EZH2 may play a role in the hematopoietic and central nervous systems. Mutations affecting EZH2 can cause Weaver syndrome (WVS).
仅用于科研。不用于诊断过程。未经明确授权不得转售。
篇参考文献 (0)
生物信息学
蛋白别名: an; Enhancer of zeste homolog 2; ENX 1; ENX-1; EZH 2; EZH-2; Histone-lysine N-methyltransferase EZH2; Lysine N-methyltransferase 6; OTTHUMP00000213774; OTTHUMP00000213778; OTTHUMP00000213779; OTTHUMP00000213780
基因别名: ENX-1; ENX1; EZH1; EZH2; EZH2b; KMT6; KMT6A; WVS; WVS2
UniProt ID: (Human) Q15910
Entrez Gene ID: (Human) 2146